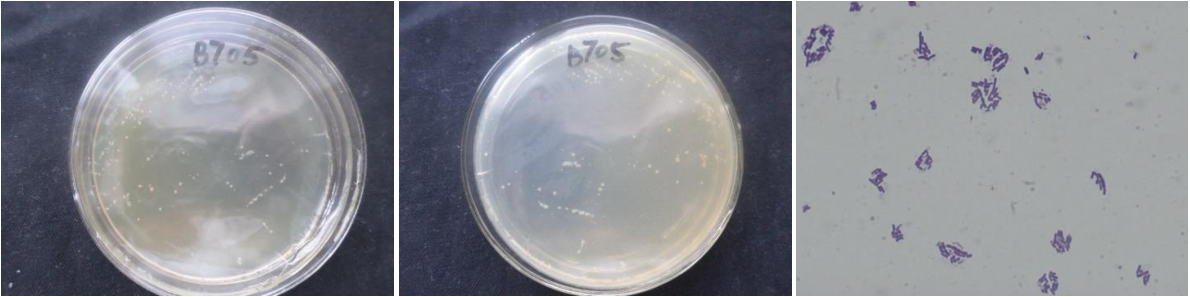

Loading...
| StrainNO | B705 |
| Classification | Bacillus |
| 16s rDNA sequence | CGTGCTATACATGCAAGTCGAGCGGACGGATGGGAGCTTGCTCCCTGAAGTCAGCGGCGGACGGGTGAGTAACACGTGGGCAAC CTGCCTGTAAGACTGGGATAACTTCGGGAAACCGGAGCTAATACCGGATAATTCTTTCCCTCACATGAGGGAAAGCTGAAAGAT GGTTTCGGCTATCACTTACAGATGGGCCCGCGGCGCATTAGCTAGTTGGTGAGGTAACGGCTCACCAAGGCAACGATGCGTAGC CGACCTGAGAGGGTGATCGGCCACACTGGGACTGAGACACGGCCCAGACTCCTACGGGAGGCAGCAGTAGGGAATCTTCCGCAA TGGACGAAAGTCTGACGGAGCAACGCCGCGTGAGTGATGAAGGTTTTCGGATCGTAAAACTCTGTTGTTAGGGAAGAACAAGTA CCGGAGTAACTGCCGGTACCTTGACGGTACCTAACCAGAAAGCCACGGCTAACTACGTGCCAGCAGCCGCGGTAATACGTAGGT GGCAAGCGTTGTCCGGAATTATTGGGCGTAAAGCGCGCGCAGGCGGTTCCTTAAGTCTGATGTGAAAGCCCACGGCTCAACCGT GGAGGGTCATTGGAAACTGGGGAACTTGAGTGCAGAAGAGAAGAGTGGAATTCCACGTGTAGCGGTGAAATGCGTAGAGATGTG GAGGAACACCAGTGGCGAAGGCGACTCTTTGGTCTGTAACTGACGCTGAGGCGCGAAAGCGTGGGGAGCAAACAGGATTAGATA CCCTGGTAGTCCACGCCGTAAACGATGAGTGCTAAGTGTTAGAGGGTTTCCGCCCTTTAGTGCTGCAGCAAACGCATTAAGCAC TCCGCCTGGGGAGTACGGCCGCAAGGCTGAAACTCAAAGGAATTGACGGGGGCCCGCACAAGCGGTGGAGCATGTGGTTTAATT CGAAGCAACGCGAAGAACCTTACCAGGTCTTGACATCTCCTGACAACCCTAGAGATAGGGCGTTCCCCTTCGGGGGACAGGATGACAGGTGGTGCATGGTTGTCGTCAGCTCGTGTCGTGAGATGTTGGGTTAAGTCCCGCAACGAGCGCAACCCTTGATCTTAGTTG CCAGCATTCAGTTGGGCACTCTAAGGTGACTGCCGGTGACAAACCGGAGGAAGGTGGGGATGACGTCAAATCATCATGCCCCTT ATGACCTGGGCTACACACGTGCTACAATGGATGGTACAAAGGGCTGCGAGACCGCGAGGTTAAGCGAATCCCATAAAACCATTC TCAGTTCGGATTGCAGGCTGCAACTCGCCTGCATGAAGCCGGAATCGCTAGTAATCGCGGATCAGCATGCCGCGGTGAATACGT TCCCGGGCCTTGTACACACCGCCCGTCACACCACGAGAGTTTGTAACACCCGAAGTCGGTGGGGTAACCTTTTGGAGCCAGCCG CCTAAGGT |
| Strain Morphology Photos | |
| Morphological Description | The morphology of Colony round;clam white;edge neatly;steamed bun shapedslippy;sticky;The morphology of strain:Rod;having spore;bias in budding spores |